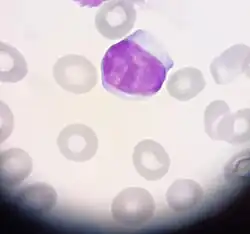

Leucemia linfoide aguda
| Leucemia linfocítica aguda | ||
|---|---|---|
![]() Frote sanguíneo mostrando linfocitos (morados) en una LLA. | ||
| Especialidad | oncología | |
| Sinónimos | ||
| Leucemia linfoblástica aguda, Leucemia linfoide aguda, LLA. | ||
La leucemia linfocítica aguda, leucemia linfoblástica aguda o leucemia linfoide aguda (LLA) comprende un grupo de neoplasias malignas que afectan los precursores (blastos)[1] de los linfocitos en la médula ósea. La mayoría son tumores de células progenitoras pre-B aunque ocasionalmente se manifiestan LLA de células pre-T. La LLA ocurre con gran frecuencia en la primera década de vida, y aumenta de nuevo el riesgo en la edad madura.[2]
Este tipo de cáncer se ha posicionado como el tipo de cáncer infantil más común hoy en día.
Clasificación
Las leucemias linfoides agudas pueden afectar tanto a los linfocitos B, como a los linfocitos T. Por ello, las LLA se clasifican de acuerdo al tipo de linfocito que afecta:
- En la mayoría de los casos infantiles, las células involucradas tienden a ser precursores de linfocitos B y producen en sangre periférica células pequeñas denominadas L1.
- Leucemia linfoblástica precursora aguda de células T
- En la mayoría de los casos de adultos, las células involucradas tienden a ser precursores de linfocitos T y producen en sangre periférica células relativamente grandes (en comparación con un linfocito normal) denominadas L2.
- Un tercer tipo de LLA involucra linfoblastos idénticos a las células del linfoma de Burkitt, denominadas L3.[3]
Hay que tener en cuenta que dentro de cada tipo existen diversos subtipos moleculares.
Causas
La leucemia linfoide aguda (LLA) se presenta cuando el cuerpo produce un gran número de glóbulos blancos inmaduros, llamados linfoblastos. Las células cancerosas rápidamente se multiplican y reemplazan las células normales en la médula ósea, el tejido blando en el centro de los huesos que ayuda a formar las células sanguíneas. La LLA impide que se formen células sanguíneas saludables. Se pueden presentar síntomas potencialmente mortales.
Este tipo de leucemia generalmente afecta a los niños entre los 3 y los 7 años de edad y es la leucemia aguda más común en la infancia. Sin embargo, el cáncer también se puede presentar en adultos.
La mayoría de las veces, no hay una causa obvia; sin embargo, lo siguiente puede desempeñar un papel en el desarrollo de la leucemia en general:
- Ciertos problemas cromosómicos.
- Exposición a la radiación, incluso los rayos X, antes de nacer.
- Tratamiento pasado con fármacos quimioterapéuticos.
- Recibir un trasplante de médula ósea.
- Toxinas como el benceno.
Lo siguiente aumenta el riesgo de padecer leucemia linfocítica aguda:
- Síndrome de Down u otros trastornos genéticos.
- Tener algún hermano o hermana que haya padecido la enfermedad puede ser un indicio de predisposición genética.
La genética juega un papel importante en esta enfermedad y difiere entre los diferentes subtipos. Analizando una cohorte de pacientes pediátricos utilizando técnicas como la secuenciación del genoma completo, el exoma y el transcriptoma, así como el estudio de polimorfismos de un solo nucleótido, se ha descubierto que los casos de LLA pediátrica en general incluyen una media de 4 alteraciones somáticas putativas por muestra, un número muy parecido a las alteraciones genéticas conductoras que se encuentran en los cánceres adultos. Sin embargo, también se ha comprobado que varios subtipos de B-ALL tienen sólo dos o tres, probablemente debido al inicio de la enfermedad a una edad más temprana o al requerimiento de menos alteraciones secundarias en los genes involucrados.[4]
Se han identificado al menos 376 genes putativos impulsores que varían en la prevalencia entre los diferentes subtipos de LLA. Todos ellos convergen en diversas vías clave para el organismo y su alteración a menudo se relaciona con el inicio y la facilitación de la transformación maligna: perturbación de la maduración linfoide, desregulación transcripcional, regulación del ciclo celular, múltiples tipos de modificación de la cromatina y señalización de quinasas, entre otras. Además, una gran cantidad de pacientes pediátricos también albergan al menos una alteración genética que se relaciona con diversos genes impulsores del cáncer.
Diversas observaciones recientes apoyan un modelo para el desarrollo de la mayoría de los subtipos de B-LLA infantiles en el que la aneuploidía o las translocaciones oncogénicas en las primeras etapas de la vida son los acontecimientos leucemógenos iniciales. Estos van seguidos por deleciones focales, incluyendo deleciones mediadas por RAG, un subproducto de la expansión linfoide que acompaña a la maduración de la respuesta inmune en la infancia.[4]
También se ha visto que las deleciones focales son más prevalentes en los subtipos de B-LLA, mientras que los polimorfismos de un solo nucleótido y los indel son más prevalentes en los subtipos de T-LLA.
Síntomas
- El que los linfocitos estén incapacitados para ejercer sus funciones, predispone al paciente a las infecciones.[5]
- La sobrepoblación linfoblástica en la médula ósea deja poco espacio físico para la producción de otras líneas celulares, por lo que es frecuente ver anemia (disminución de los hematíes) y trombopenia (disminución de las plaquetas), que causan hemorragias.[6]
Pronóstico
Casi el 75 % de los adultos tratados para la LLA logran una remisión completa (RC), y del 20 al 40 % se curan. En los niños, 90 % logran una remisión completa y entre el 60 y el 85 % se curan.
Las diferencias en las respuestas de adultos y niños se deben a las variaciones en la biología de la enfermedad. Por lo general, los indicadores para el pronóstico de los adultos con LLA son desfavorables, por ello su respuesta es distinta a la que se observa en la población infantil.
- Edad. Los bebés menores de un año y los niños mayores de diez tienen un pronóstico peor que los que tienen entre y uno o nueve años. Los adultos tienen un resultado menos favorable que los pequeños y el peor pronóstico es para los mayores de 60 años.
- Sexo. Los varones, ya sean adultos o niños, tienen una tasa de supervivencia menor a largo plazo. Las recidivas testiculares pueden ser las responsables de la disminución de la supervivencia en los niños con LLA.
- Citogenética. Las características citogenéticas son los factores más importantes que influyen en el pronóstico de la LLA. Las anomalías pueden ser estructurales o relacionarse con el número de cromosomas. En los niños, la ploidía es el factor más importante para el pronóstico; el más favorable es para quienes tienen más de 50 cromosomas. La translocación del cromosoma Filadelfia (9;22) en los adultos se manifiesta en un 30 % de los afectados e indica un pronóstico peor.
Tratamiento
El objetivo del tratamiento en la LLA es lograr la curación. Los regímenes estándar para esta enfermedad constan de dos fases: la terapia de inducción y la terapia posterior a la remisión; ambas incorporan el tratamiento profiláctico para evitar la afección del sistema nervioso central.
El propósito de la terapia de inducción es obtener una remisión completa. La terapia posterior a la remisión se administra durante dos o tres años después de la remisión completa con el fin de erradicar cualquier remanente de células leucémicas no detectables clínicamente que puedan causar una recidiva.
Terapia de inducción
Los principales agentes quimioterapéuticos utilizados para inducir la remisión son: 1) la vincristina, 2) un corticosteroide (por lo general prednisona), y 3) una antraciclina (doxorrubicina o daunorrubicina). Las tasas de remisión varían entre el 70 y el 85 % con un índice de mortalidad bajo debido a la inducción. Otros regímenes utilizan medicamentos adicionales (L-asparaginasa, ciclofosfamida, metotrexate, mercaptopurina, citarabina [ARA-C]), aunque no parece que aumenten las tasas de respuesta. Una excepción parece ser la LLA de células B maduras, que puede responder al empleo de altas dosis de ciclofosfamida combinada con Vp16 alternadas con dosis altas de metotrexate y ARA-C combinada con Vp16.
Tratamiento del sistema nervioso central: El SNC puede servir como un "santuario" para las células leucémicas. En el momento del diagnóstico se observa afección leucémica del LCR en el 5 % de los niños y menos del 10 % de los adultos. Sin embargo, si no se administra un tratamiento para el SNC, este se verá afectado hasta el 50 a 75 % de los adultos. El tratamiento se basa en la radiación craneal combinada con la quimioterapia intratecal que puede producir efectos secundarios importantes. Los pacientes con leucemia del SNC deben recibir un tratamiento más radical, que incluya quimioterapia intraventricular y radiación craneal.
Terapia de mantenimiento
- Un programa ampliado de terapia de mantenimiento con dosis semanales bajas de 6-mercaptopurina (6-MP) y metotrexate, durante dos o tres años, es eficaz para evitar la recaída y mejorar la supervivencia en los niños. Por lo general se usa una combinación de diversos agentes antileucémicos además de 6-MP y metotrexate.
- Trasplante de médula ósea: El momento adecuado para realizar el trasplante alogénico de médula ósea (médula de un donante histocompatible) y su impacto en la LLA de los adultos siguen siendo objeto de controversia. No está claro si este trasplante ofrece una ventaja a los pacientes con esta enfermedad y un pronóstico favorable. Los individuos con LLA y cromosoma Filadelfia tienen una supervivencia sin enfermedad de 38 % cuando reciben un trasplante de médula ósea (TMO) durante la primera remisión completa.
- Terapia para la enfermedad recurrente: La mayoría de las recidivas de la LLA se producen en los primeros dos años de la remisión. Hasta la mitad de los pacientes con recurrencia pueden lograr una segunda remisión si se repite el régimen original de inducción. Los enfermos con recidiva posterior a la terapia de mantenimiento tienen una mayor probabilidad de lograr una segunda remisión que aquellos que hacen la recurrencia simultánea a la terapia.
Referencias
Portal:medicina. Contenido relacionado con medicina.
- ↑ Instituto Nacional de Câncer. [1] Archivado el 19 de junio de 2007 en Wayback Machine.
- ↑ The Leukemia and Linfoma Society. [2]
- ↑ Leucemia linfoide aguda: estudio citogenético en niños atendidos en el Hospital Universitario San Vicente de Paúl de Medellín en el período 1998-2001. IATREIA, VOL 15, No.4, DICIEMBRE 2001 [3]
- ↑ a b Brady, Samuel W.; Roberts, Kathryn G.; Gu, Zhaohui; Shi, Lei; Pounds, Stanley; Pei, Deqing; Cheng, Cheng; Dai, Yunfeng et al. (2022-09). «The genomic landscape of pediatric acute lymphoblastic leukemia». Nature Genetics (en inglés) 54 (9): 1376-1389. ISSN 1546-1718. doi:10.1038/s41588-022-01159-z.
- ↑ Associaçao Brasileira de Linfoma e Leucemia. [4]
- ↑ National Cancer Institute. [5]
